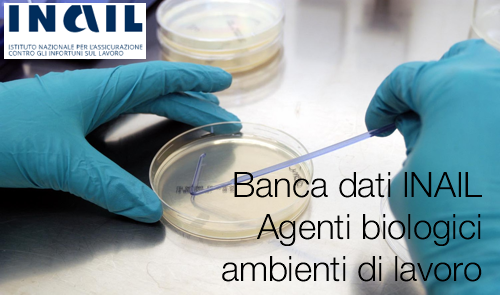
Banca dati INAIL Banca dati INAIL

Banca dati INAIL: Agenti biologici e ambienti di lavoro
| ID 5655 | | Visite: 6113 | News | Permalink: https://www.certifico.com/id/5655 |
Agenti biologici e ambienti di lavoro, online la nuova Banca dati Inail
INAIL 19 Febbraio 2018
Realizzata dalla Consulenza tecnica accertamento rischi e prevenzione e dalla Direzione centrale organizzazione digitale, è destinata a favorire la conoscenza del rischio biologico e dei livelli di contaminazione microbiologica associati alle varie mansioni lavorative, mettendo a disposizione informazioni utili per la prevenzione e fornendo uno strumento valido per l’autocontrollo aziendale.
Gestire il processo di rilevazione della contaminazione microbiologica ambientale, archiviare i risultati derivanti dalle indagini e valutarli allo scopo di prevenire i rischi e per attuare il controllo statistico della qualità del dato analitico. Queste le finalità della Banca dati agenti biologici e agenti di lavoro, il nuovo software Inail sviluppato dalla Consulenza tecnica accertamento rischi e prevenzione (Contarp) e dalla Direzione centrale organizzazione digitale (Dcod).
I risultati delle indagini ambientali organizzati per settori e attività produttive. All’interno dell’applicativo, disponibile sul portale dell’Istituto nell’area dei servizi online dedicata al rischio biologico, sono raccolti e organizzati, per settori e attività produttive, le indagini ambientali condotte, i livelli di biocontaminazione riscontrati nelle diverse fasi lavorative e le informazioni sul comparto produttivo, utili alla sua caratterizzazione. Nel software è prevista, inoltre, la valutazione dei risultati delle indagini, per il controllo statistico automatico della qualità del dato analitico, ed è presente una sezione in cui è possibile archiviare documenti, immagini e video relativi ai monitoraggi condotti.
Una rete per migliorare la conoscenza. La Banca dati è destinata a strutture pubbliche ed enti interessati ad archiviare i dati e le informazioni derivanti dalle proprie indagini ambientali, per creare una rete che consenta di migliorare la conoscenza, a scopo preventivo, del rischio biologico occupazionale. L'applicativo fornisce, inoltre, uno strumento valido ai fini dell’autocontrollo microbiologico aziendale, nell’ambito dei processi interni di prevenzione e dell’archiviazione dei dati acquisiti attraverso di esso.
La registrazione al portale requisito preliminare. Per utilizzare il software, se non si dispone delle credenziali Spid (Sistema pubblico di identità digitale), Inps o Carta nazionale dei servizi, è necessario registrarsi al portale Inail come utente con credenziali dispositive, inviando successivamente la richiesta di accesso alla Banca dati attraverso la posta elettronica certificata della struttura di appartenenza.
Previsti due profili di accesso. Nella richiesta deve essere indicato anche il profilo con cui si intende accedere all’applicativo: chiunque sia interessato alla consultazione dell’archivio, con la possibilità di visionare solo una sintesi dei dati, può registrarsi come “visualizzatore”, mentre il personale tecnico che effettua indagini ambientali e intende utilizzare il software per archiviare i propri dati, oltre a visualizzare i monitoraggi eseguiti da altri tecnici, può chiedere l’accesso con il profilo di “utilizzatore”.
Valutazione del rischio
Per stimare l'entità del rischio da esposizione ad agenti biologici, nel processo di valutazione è necessario:
- identificare i pericoli anche potenziali
- stimare la gravità delle conseguenze derivanti dall'esposizione a tali pericoli
- identificare e quantificare i soggetti esposti
- misurare l'entità di tale esposizione.
La valutazione del rischio biologico presenta tuttavia aspetti di incertezza notevoli, legati principalmente alla grande varietà di agenti da valutare, molti dei quali caratterizzati da complesse interazioni interspecifiche e ambientali che possono favorirne o limitarne la proliferazione, e alla diversa risposta di ciascun individuo all'esposizione.
Riguardo quest'ultimo punto, infatti, la valutazione del rischio deve tenere conto di tutti i lavoratori anche quelli temporanenamente o stabilmente più sensibili, quali ad esempio coloro che presentano una diminuzione delle difese immunitarie o le donne in gravidanza. Sarebbe molto utile, in fase di analisi dei rischi, conoscere
- la modalità di interazione microrganismo-ospite
- il ciclo complessivo dell'infezione
- eventuali fattori favorenti l'infezione o in grado di aumentare la patogenicità
- la misura esatta della dose.
Tali informazioni, però, non sempre sono disponibili; la stima dell'esposizione, per esempio, valutabile attraverso la misura della contaminazione ambientale, presenta notevoli aspetti di incertezza: mancano metodiche di monitoraggio standardizzate, i dati sono spesso dispersi e non esistono valori limite di esposizione affidabili e definiti.
Inoltre, per la maggior parte degli agenti biologici non sono note le relazioni dose - effetto e dunque non si possono "definire" dosi utilizzabili come valori limite di esposizione. Ai fini preventivi, è comunemente adottato l'assunto conservativo secondo il quale non esiste una soglia di infettività, cioè è sufficiente anche un solo microrganismo a provocare l'infezione (Dose Minima Infettante, DI0 = 1) e, quando questa condizione è abbinata ad una elevata patogenicità (capacità di indurre una malattia in seguito ad infezione), trasmissibilità (capacità di essere trasmesso da un soggetto portatore ad un soggetto non infetto) e limitata neutralizzabilità (disponibilità di misure profilattiche o terapeutiche), l'unico intervento efficace per la prevenzione del rischio risulta l'eliminazione dell'esposizione.
Al termine del processo di valutazione del rischio il datore di lavoro è tenuto a predisporre gli interventi necessari alla riduzione, o eliminazione laddove possibile, dell'esposizione agli agenti biologici pericolosi e ad adottare le misure di prevenzione e protezione più idonee, commisurate all'entità del rischio.
...
Destinatari del prodotto
Il prodotto è rivolto a quanti sono interessati ad archiviare dati e informazioni derivanti da proprie indagini ambientali, utili alla conoscenza, a scopo preventivo, del rischio biologico occupazionale.
Sono previsti due profili di accesso riservati a enti e strutture pubbliche:
- visualizzatori: chiunque sia interessato alla consultazione dell’archivio potrà visionare solo una sintesi dei dati
- utilizzatori: personale tecnico che effettui indagini ambientali e intenda utilizzare la procedura per archiviare i propri dati. Gli utilizzatori sono anche visualizzatori dei monitoraggi eseguiti da altri tecnici.
- archiviazione di dati derivanti dalle indagini
- valutazione dei risultati ai fini prevenzionali e del controllo statistico della qualità del dato analitico.
- fornisce uno strumento valido ai fini dell’autocontrollo microbiologico aziendale, nell’ambito dei processi interni di prevenzione e dell’archiviazione dei dati acquisiti nell’attività di verifica.
Struttura dell’applicativo
In particolare, l’insieme di dati attraverso cui organizzare le informazioni sul monitoraggio e i luoghi di lavoro include:
- dati sul monitoraggio ambientale (oggetto del campionamento: aria, superfici, acqua con possibilità di archiviare dati relativi al campionamento di altre tipologie, microclima)
- risultati del monitoraggio; nel software è prevista la valutazione del risultato per il controllo statistico in automatico della qualità del dato analitico. Tale sezione è stata realizzata dalla Consulenza statistico attuariale dell’Inail
- una sintesi dei dati raccolti, il cui scopo è consentire all’utenza di leggere e salvare informazioni, per meglio comprendere il fenomeno del rischio biologico occupazionale
- documenti, immagini e video relativi alle indagini ambientali condotte.
Requisiti per accesso